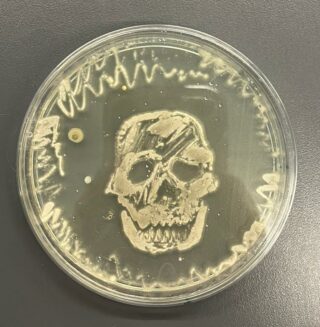

Toimintaa ja tapahtumia
CERN-tiedeleirikoulun blogi 13.-18.4.2026
18 lyseolaista (16 opiskelijaa + kaksi opettajaa) viettää huhtikuisen viikon Sveitsissä. Tutustumme kaupungin lisäksi maailman suurimpaan hiukkaskiihdyttimeen ja sillä tehtävään tutkimukseen CERNissä, fuusioenergian tutkimukseen Swiss Plasma Centerissä ja Lausannen kaupunkiin. Matkaamme tukee Lahden kaupungin lisäksi Padasjoen säästöpankkisäätiö!
Pääset seuraamaan reissuamme opiskelijoiden kirjoittamasta blogista. Tästä blogiin ->
Hiukkasfysiikan seminaari Jyväskylässä
Lyseon kaikki fysiikan abiturientit matkasivat Jyväskylään hiukkasfysiikan lukiolaisseminaariin. Mukaan mahtui myös muutama innokas kakkosluokkalainen! Kuulimme luentoja CERNissä tehtävästä tutkimuksesta – kun protonin vauhti kiihdytetään hyvin lähelle (yli 99 %) valonnopeudesta, sen kvarkki- ja gluonisisällölle tapahtuu kummia… Lisäksi pääsimme tutustumaan kiihdytinlaboratorioon, nanolaboratorioon ja röntgentomografiaan.
Menestys luo motivaatiota
Elias ei uskonut päätyvänsä kemiaolympialaisiin
Lahden lyseosta tällä viikolla valmistuva hollolalainen Elias Tanhua ei vuosi sitten tiennyt, mistä itsensä pian löytää. Omaan osaamiseensa vaatimattomasti suhtautuva Elias on yksi neljästä suomalaisnuoresta, jotka suuntaavat heinäkuussa Arabiemiraatteihin vertailemaan taitojaan kansainvälisen opiskelijakärjen kanssa kemian olympialaisissa (IChO, International Chemistry Olympiad).
Kisapolku alkoi syksyn 2024 kansallisessa kemiakilpailussa kemian opettajan aloitteesta.
– Aluksi en ollut kovin motivoitunut koko kilpailun suhteen. En ollut lukion kurssien aikana kovin hyvä kemiassa tai juurikaan innostunut siitä. Opettajani esittämästä kutsusta en kuitenkaan kehdannut kieltäytyä. Tavallaan minua kiinnosti myös omien taitojeni testaaminen, Elias muistelee.
– Koe meni hyvin, ja minut kutsuttiin muutaman päivän mittaiselle Helsingin Yliopiston tiloissa järjestetylle valmennusleirille. En kehdannut kieltäytyä myöskään kutsusta leirille, jolle kaverini minua kannustivat lähtemään. Leirin jälkeen osallistujille annettiin kotitehtäviä, joiden tekemiseen en suhtautunut aluksi kovin innostuneesti, koska en ajatellut voivani päästä olympialaisiin asti.
Usko omiin taitoihin kasvoi kuitenkin pian kisakokemuksen karttuessa ja osaamisen syventyessä.
– Vähän ensimmäisen leirin jälkeen järjestettiin kemian loppukilpailu, jossa tulin toiseksi. Rahapalkinnon ja tarjottujen tekniikan alan opiskelupaikkojen lisäksi sain sijoituksestani paljon motivaatiota. Kevään kirjoitusten jälkeen meille lähetettiin lisää tehtäviä, tällä kertaa enemmän tulevien kemiaolympialaisten aihepiireihin liittyviä. Jälkimmäiset tehtävät olivat ainakin minulle vaikeita, mutta niitä varten opiskeleminen auttoi oikeasti ymmärtämään niitä asioita, joita lukiossa yritin vain muistaa, Elias kertoo.
– Tehtävien tekemistä jatkettiin toukokuussa järjestetyllä toisella leirillä, jonka päätteeksi järjestettiin joukkueenvalintakoe. Koe sisälsi sekä laboratoriossa tehdyn kokeellisen että paperilla tehdyn teoriaa käsittelevän osan. Yllätyksekseni tulin yhdeksästä kilpailijasta ensimmäiseksi, ja seuraavaksi sainkin jo sähköpostiini lentolipun Dubaihin.
Kisamenestyksen lisäksi kiinnostusta kasvattivat uudenlaiset laboratoriotyöt ja eri tieteenalojen sekoittuminen.
– Minua kiinnostaa lähes kaikki luonnontieteisiin liittyvä. Leirien pitkät oppitunnit olivat ajoittain tylsistyttäviä, ja joidenkin vaikeiden kotitehtävien tekeminen saattoi välillä olla turhauttavaa – niissä onnistuminen oli sitäkin palkitsevampaa! Pidin siitä, että näissä tehtävissä kemia sekoittui fysiikkaan, biologiaan ja matematiikkaan paljon enemmän kuin lukion oppimäärässä, Elias toteaa.
– Etenkin laboratoriossa tehtävät työt olivat mielenkiintoisia, ja niitä minun varmaan tulee ikävä. Yliopiston välineet ja laboratoriot mahdollistivat paljon muitakin kokeellisia töitä kuin niitä, joita lukiossa saimme tehdä. Parasta leireillä kuitenkin olivat siellä saamani kaverit, joita tulen näkemään vielä Dubaissa ja myöhemmin opintojeni aikana yliopistolla.
Suomen nelihenkiseen joukkueeseen kuuluu Eliaksen lisäksi kaksi opiskelijaa pääkaupunkiseudulta ja yksi Tampereelta. Joukkueen valintaa ja valmennusta koordinoidaan Helsingin yliopistosta. Ennen loppukoitosta Eliasta odottaa itsenäisen valmentautumisen lisäksi vielä yhteispohjoismaiset kemiakilpailut (NChO) Göteborgissa.
Suomessa tiedeolympialaisten valmennus on varsin kevyttä moniin kilpailijamaihin verrattuna, ja Elias suhtautuu mahdollisuuksiinsa varovaisesti.
– Olen ymmärtänyt kilpailun olevan niin kovaa, ettei kovakaan lukeminen takaa mitään menestystä. Mitään tavoitteita en itselleni siis uskalla asettaa. Nähtäväksi jää, kuinka paljon jaksan enää kisoihin harjoitella. En aio stressata tai ottaa liikaa paineita kisoista. Suurin työ on jo tehty, eikä tässä ole muutenkaan paljoa aikaa ennen heinäkuussa järjestettäviä kisoja. Ei oikeastaan haittaisi, vaikka tulisin viimeiseksi, Elias väittää.
Jos kisatavoitteita ei lausutakaan ainakaan ääneen, sen jälkeiset tavoitteet elämässä ovat selkeytyneet.
– Päätös oli vaikea. Voisin kuvitella itseni opiskelemassa fysiikkaa, kemiaa tai matematiikkaa, ja aiemmin suunnittelinkin tekniikan alalle hakemista. Työnkuvan puolesta eniten kuitenkin kiinnostaa lääketiede. Haenkin nyt pääsykokeella Helsingin lääkikseen, jonne en laudatur-rivistäni huolimatta pääse todistusvalinnassa, koska en ehtinyt kirjoittaa biologiaa.
– Kisavalmentautuminen tukee hyvin myös pääsykokeeseen valmistautumista, ja uskon pääseväni sisään valintakokeen kautta. Olen silti myös varautunut täydentämään arvosanojani kirjoittamalla biologian ensi syksynä. Opinnot alkavat joka tapauksessa vasta vuoden päästä, koska menen heti kemiaolympialaisten jälkeen armeijaan.
Kansainväliset kemian olympialaiset on lukioikäisille tarkoitettu vuosittainen suurtapahtuma, joka järjestetään ensi heinäkuussa 57. kerran, tällä kertaa Arabiemiraateissa. Osallistujia on 1000, ja he tulevat 90 maasta. Kahden kisapäivän lisäksi luvassa on myös erilaisia retkiä ja vierailuja paikallisiin kulttuuri- ja tiedekohteisiin sekä vapaata yhdessäoloa. Yhteispohjoismaiset kemiakilpailut (NChO) aloitettiin 2016 parantamaan Pohjoismaiden menestystä IChO:ssa. Tämä kilpailu järjestetään edustusjoukkueille juuri ennen IChO:ta.
Pärjäisitkö sinä kemiakilpailuissa? Tutustu valmennukseen ja esimerkkitehtäviin Suomen kemian olympiavalmennuksen verkkosivuilla: Kansainväliset kemiakilpailut – Kemian valmennus
Kemiaolympialaisten verkkosivut (englanniksi): IChO 2025 UAE | International Chemistry Olympiad
Lisätietoa luonnontieteiden kilpailutoiminnasta:
Galakseja ja mäntymetsiä tiedeleirikoulussa
NOT-koulu on Turun yliopiston Tiedekeskuksen, Lounais-Suomen LUMA-keskuksen ja Suomen ESO -keskuksen lukiolaisille järjestämä tähtieteen kurssi, jonka aikana opimme paljon tähtitieteestä ja sen tutkimuksesta. Lahden lyseosta meitä lähti tänä vuonna mukaan kymmenen kiinnostuksen mukaan valittua oppilasta opettajanamme Johanna Joensuu. Matkamme oli 27.10-4.11.2023, josta viisi kokonaista päivää vietimme La Palman saarella. Ennen varsinaista matkaa saimme perustietoja etäluennoilla, ja valitsimme kohteet, joita halusimme kuvata Nordic Optical Telescope:lla (NOT). Matkan aikana kävimme tutustumassa myös Gran Telescopio Canarias:iin (GTC) sekä kahteen Cherenkov-teleskooppiin (MAGIC).
Havaintoyötä edeltävänä päivänä lähdimme heti aamusta bussilla serpentiiniteitä pitkin Roque de los Muchachos -vuorelle. Kävimme ensin vierailukeskuksessa, jossa saimme tietoa La Palman muista teleskoopeista sekä saaresta tähtitieteen kannalta. Opimme esim. valosaasteen määrän ja muiden näkyvyyttä haittaavien tekijöiden säätelystä sekä saaren ideaalista ilmastosta. Tämän jälkeen menimme NOT:lle, pohjoismaiden omistamalle optiselle teleskoopille, jossa meille esiteltiin itse teleskooppia sekä sen toimintaa ja käyttöä. Tämän jälkeen vierailimme MAGIC-teleskoopeilla, jotka havainnoivat ilmakehän gamma-aaltopurkauksia. Siellä meille kerrottiin teleskooppien toimintaperiaatteesta ja näytettiin, kuinka ne käynnistetään. Seuraavaksi pääsimme katsomaan GTC:tä, joka on tällä hetkellä maailman suurin yksiaukkoinen optinen teleskooppi. Sanomattakin on selvää, että se oli NOT:ia suurempi ja siksi vaikuttava.
Auringon laskiessa siirryimme takaisin NOT:lle tekemään omia havaintojamme. Valvoimme koko yön (ainakin melkein) ja jokainen ryhmä kuvasi omilla vuoroillaan valitsemiaan kohteita. Kun kaikki oli suunniteltu hyvin jo etukäteen, oli toiminen teleskoopilla sujuvaa. Yön aikana meillä oli apunamme tähtitieteilijä Pasi Nurmi sekä opiskelija Mikael Turkki. NOT:n toiminnasta oli kertomassa myös Tapio Pursimo. Kuvat käsiteltiin matkan jälkeen Suomeen palattuamme, ja esiteltiin muille ryhmille loppuseminaarissa.
Tähtitieteen lisäksi ehdimme tutustua hyvin La Palman erityislaatuiseen luontoon sekä suloisen pieneen pääkaupunkiin. Johanna piti meille luennon saaren alkuperästä, sen omalaatuisesta lajistosta ja tulivuorista, mikä antoi hyvät lähtökohdat luonnon tarkkailulle vaelluksella. Bussi vei meidät aamulla vaellusreitin lähtöpisteeseen, ja haki päivän päätteeksi määränpäästä. Reitin alkupuoli oli pääsääntöisesti nousua (400 nousumetriä), ja korkein kohta oli n. 1900 m korkeudessa. Matkan loppupuoli oli onneksi suurimmaksi osaksi laskua. Aikaa oli varattu runsaasti, ja siksi oli mahdollista kävellä rauhallista tahtia upeita maisemia ihastellen. Mieleen jäivät aikaisempien tulivuorenpurkausten jäljet, ruokaa kerjäävät korpit, korkeat näköalapaikat ja täydellinen sää. Huipulla näkymät olivat upeat: Teneriffan vuori Teide kaukaisuudessa, merta silmänkantamattomiin ja kanarianmäntyjen peittämät rinteet.
Teimme myös muutaman tunnin reissun pääkaupunkiin, jonka aikana kiertelimme kauppoja ja pikkukatuja sekä ostimme tuliaisia. Bussipysäkin viereisestä muurista pilkistävät liskot jäivät huvittavuudessaan mieleen. Kävimme useampaan otteeseen uimassa ja katsomassa rapuja hotellin viereisellä rannalla, jonka hiekka oli pikimustaa kaikkien muiden rantojen tavoin. Iltaisin teimme hotellin lähiympäristössä kävelyretkiä, joiden aikana katselimme tähtitaivasta.
Matkustimme yhtä aikaa Helsingin luonnontiedelukion opiskelijoiden kanssa, ja mukana oli opiskelijoita myös Otaniemen lukiosta, Helsingin Suomalaisesta Yhteiskoulusta ja Hyvinkään lukiosta. Saimme kaikki ainutlaatuisen kokemuksen, ja siitä lämmin kiitos kuuluu matkan järjestelyissä mukana olleille, kanssaopiskelijoille, opettajille sekä erityisesti matkamme rahallisille tukijoille: Lahden kaupungille, Otto A. Malmin rahastolle, Padasjoen säästöpankkisäätiölle ja herkkumyyntiin osallistuneille.
Teksti: Kreetta Maisniemi, Sara Muhonen ja Hilma Sipilä
Koe Aalto-kampus! 2023 ja Aalto-yliopiston teknillisen fysiikan ja matematiikan opiskelijat lyseolla
Koe Aalto-kampus! -tapahtuma 4.10.2023 tarjosi lukiolaisille mahdollisuuden tutustua Aalto-yliopistoon pintaa syvemmältä.
Osallistujat pääsivät kiertämään kampuksella, kurkistamaan suljettujen ovien taakse studioihin, laboratorioihin ja luentosaleihin, tapaamaan opiskelijoita, tutustumaan opetukseen ja osallistumaan miniluennoille ja infotilaisuuksiin.
Harppi-festarit lukiolaisille 2020-2023
Lukion matematiikan ja luonnontieteiden kehittämisverkosto järjestää Suomen luonnontiedelukiolaisille monenlaista toimintaa. Yhdeksi suosituimmaksi tapahtumaksi on noussut matematiikka- ja tiedefestarit eli Harppi-festarit, jotka on järjestetty Maunulan yhteiskoulun ja Helsingin matematiikkalukiossa neljänä peräkkäisenä syksynä.
Festareilla on matematiikkaa, tiedettä, hyviä tyyppejä, rentoa yhdessäoloa, mielenkiintoisia puhujia, mahtavia työpajoja, lautapelejä, maukasta ruokaa ja vaikka mitä muuta! Tiedossa on siis kaikkinensa tervehenkistä ja mahtavaa festarimeininkiä lukiolaisille ja heidän opettajilleen. 🙂
Ajankohtaista fysiikasta -opintojaksolla rakenneltiin satelliitteja ja käytiin Helsingin yliopiston fysiikan laitoksella
Satelliittitunnin veti Heurekan kouluttaja. Kumpulassa tutustuttiin Helsingin yliopiston hiukkasfysiikan kiihdytinlaboratorioon ja kuultiin avaruusfysiikan tutkimuksen kuulumisia.
Lyseon nuorten fysiikkataiturien tähtäin on Tokiossa
Lahden lyseon abiturientit Oskari Virtanen ja Aaron Piipponen tekivät ehkä lahtelaista opiskelijahistoriaa kuittaamalla kaksi viidestä Suomen joukkueen paikasta kansainvälisiin fysiikkaolympialaisiin. Paikat kisakoneeseen varmistuivat Pohjoismaiden ja Baltian karsintakilpailuissa Tallinnassa viime viikonloppuna.
Oskari sai karsinnassa suomalaislukioiden edustajista toiseksi parhaat pisteet ja saavutti pronssimitalitason. Aaron oli suomalaisista viides.
Kisaan osallistui 91 opiskelijaa yhdeksästä maasta. Pohjoismaiden ja Baltian lisäksi mukana oli kilpailijoita muun muassa Saudi-Arabiasta, sillä tätä Koillis-Euroopan karsintakisaa pidetään kansainvälisesti erittäin kovatasoisena. Toista kertaa kisassa mukana ollut Oskari karsiutui viime vuonna täpärästi jatkosta. Aaronille kokemus oli ensimmäinen.
– Kivaahan siellä oli. Kiva porukka, jonka kanssa vapaa-aika meni mukavasti. Itse kisassa teoriaosio meni omasta mielestä hyvin, kokeelliset taas vähän mönkään, Aaron muistelee. Myös Oskari tunnistaa kokeelliset tehtävät heikoksi kohdakseen ja lisää, että karsinnassa näki konkreettisesti kansainvälisen kilpailun kovan tason.
Lahden lyseon luonnontieteiden ja matematiikan erikoislinjalla opiskelevat Aaron ja Oskari osallistuivat alkukevään aikana Jyväskylän yliopiston järjestämään valmennukseen ja pääsivät mukaan karsintakilpailuun osana 15 lukiolaisen suomalaisryhmää.
-Valmistautuminen jäi aika vähille, Aaron tunnustaa.
-Suurimmaksi osaksi katselin YouTubesta luentoja ja tein joitakin vanhoja kisatehtäviä. Kesäkisaan yritän ainakin valmistautua paremmin kuin näihin. Tulossa on myös valmennusleiri, joka toivottavasti auttaa.
Oskari arvioi käyttäneensä kisaan valmistautumiseen 100-200 tuntia joulun jälkeen. Ennen olympialaisia on luvassa lisää töitä:
-Teen vanhoja kilpailutehtäviä ja paikkaan suurimmat aukot pois teoriaosaamisestani. Jonkinlaista huomiota tulen kiinnittämään myös kokeelliseen työskentelyyn, sillä kisojen teoriatuloksellani olin 20 parhaan joukossa ja kokeellisella suoriutumisellani 20 huonoimman joukossa.
Fysiikan opinnot eivät näillä nuorilla todennäköisesti jää lukioon, vaan myös tulevaa työuraa lähdetään hakemaan omalta tuntuvasta suunnasta.
-Lähden Helsingin Yliopistoon opiskelemaan fysikaalisia tieteitä, todennäköisesti teoreettista fysiikkaa, Oskari paljastaa. Aaron on samoilla linjoilla, vaikka pohtii vielä valintaa fysiikan ja matematiikan välillä.
Kansainväliset fysiikkaolympialaiset on lukiolaisille tarkoitettu vuosittainen fysiikkakilpailu, jonka tarkoituksena on innostaa nuoria fysiikan ja luonnontieteiden opiskeluun sekä auttaa kehittämään luonnontieteiden opetusta. Kilpailu on monipäiväinen, ja mukana on sekä teoreettisia että kokeellisia tehtäviä. Olympialaisten aikana ohjelmassa on myös erilaisia retkiä ja vierailuja paikallisiin kulttuuri- ja tiedekohteisiin.
Kansainväliset fysiikkaolympialaiset pidetään ensi heinäkuussa Tokiossa.
Onnea ainutlaatuisen upeasta suorituksesta ja tsemppiä jatkoon!
Menestystä Harppi-tiedekilpailussa
Harppi-tiedekilpailun finaalissa lyseon joukkue ylsi kolmossijalle. Finaalissa testattiin teoriatiedon lisäksi käytännön luonnontiedetaitoja, ja näiltähän niitä(kin) löytyy!
Hopeasija kansallisessa fysiikkakilpailussa
Lahden lyseon abiturientti Oskari Virtanen saavutti upeasti toisen sijan MAOLin kansallisessa fysiikkakilpailussa. Toista kertaa kisassa mukana ollut Oskari kertoo yllättyneensä nähtyään tulosluettelon:
– Kisan aikana ei tuntunut siltä, että nyt menee hyvin, mutta ilmeisesti tehtävät olivat muillekin vaikeita!
Palkinnoksi menestyksestä Oskari kuittaa rahapalkinnon lisäksi opiskelupaikan tekniikan tai matemaattis-luonnontieteelliseltä alalta. Hän on mukana myös fysiikan olympiavalmennuksessa, jossa tavoitteena on paikka Suomen joukkueessa Pohjoismaiden ja Baltian valintakilpailussa.
-Tavoitteena on sijoittua valintakilpailussa niin hyvin, että pääsen Suomen joukkueeseen fysiikkaolympialaisiin, jotka pidetään Japanissa.
Onnea hienosta suorituksesta ja tsemppiä jatkoon!
Menestystä Harppi-tiedekilpailussa
Lyseon joukkue sijoittui hienosti toiseksi Harppi-tiedekilpailun alkukilpailussa ja pääsee suorituksellaan finaaliin. Lahden lyseon joukkueessa kisasivat Ilja Afroskin, Aaron Piipponen, Tommi Suikki, Ville Tiensuu ja Oskari Virtanen. Onnea menestyksestä ja onnea finaaliin!
Menestystä kansallisessa biologiakilpailussa
Aito kiinnostus auttaa myös fysiikkaolympialaisissa
– Erityisen mielenkiintoisen kisasta teki sen kansainvälisyys, Oskari kertoo.
– Kokeiden välissä jäi aikaa jutella ja viettää aikaa muiden kisailijoiden kanssa, vaikka pelata korttia.
Luonnontieteiden ja matematiikan erikoislinjalla opiskeleva Oskari pääsi mukaan kilpailuun yhtenä noin 20 suomalaisnuoresta. Karsinta tehtiin kirjeitse tapahtuneen valmennuksen perusteella.
-Loppuvalmistautuminen jäi vähän viime tippaan, mutta tein vanhoja kilpailutehtäviä ja katsoin netistä mielenkiintoisia juttuja, Oskari kuvailee.
-Lainasin myös fysiikan opettajalta yhden kirjan ja lueskelin sitä.
Kansainväliset fysiikkaolympialaiset on lukiolaisille tarkoitettu vuosittainen fysiikkakilpailu, jonka tarkoituksena on innostaa nuoria fysiikan ja luonnontieteiden opiskeluun sekä auttaa kehittämään luonnontieteiden opetusta. Kilpailu on monipäiväinen, ja mukana on sekä teoreettisia että kokeellisia tehtäviä.
-Tykkäsin erityisesti tehtävästä, jossa piti määrittää laserilla kiihdytetyn raketin loppunopeus ja sen kokema kiihtyvyys. Myös ensimmäisen tehtävän asetelma jäi mieleen: siinä oltiin ydinasetestissä ja yritettiin määrittää, keretäänkö lentokoneella pakoon vai ei.
Suomalaisten lukiolaisten ja samalla karsintakilpailun kovasta tasosta kertoo se, että suomalaiset ovat vuodesta toiseen keränneet kansainvälisissä fysiikkaolympialaisissa kärkisijoja. Oskarin jatkosuunnitelmat ovat selvät.
-Jos mahdollista, yritän osallistua kisaan myös ensi vuonna, tavoitteena parantaa omaa suoritusta. Lukion jälkeen suunnitelmana on hakea Aalto-yliopistoon opiskelemaan teknillistä fysiikkaa ja matematiikkaa.
Suomessa olympiajoukkueen valintaa ja valmennusta koordinoidaan Jyväskylän yliopistosta. Normaalioloissa Pohjoismaiden ja Baltian maiden fysiikkaolympialaisissa (entinen Suomi-Viro-maaottelu) valittaisiin joukkue kansainvälisiin fysiikkaolympialaisiin. Ne oli alun perin tarkoitus järjestää Valko-Venäjällä, mikä ei nykyoloissa ole mahdollista. Valittu joukkue osallistuu siksi Sloveniassa pidettäviin Euroopan fysiikkaolympialaisiin.
Harppi-festarit
Marraskuussa 2021 lyseon LUMATE-opiskelijoita osallistui Maunulan matematiikkalukion Harppi-festareille Helsingissä.